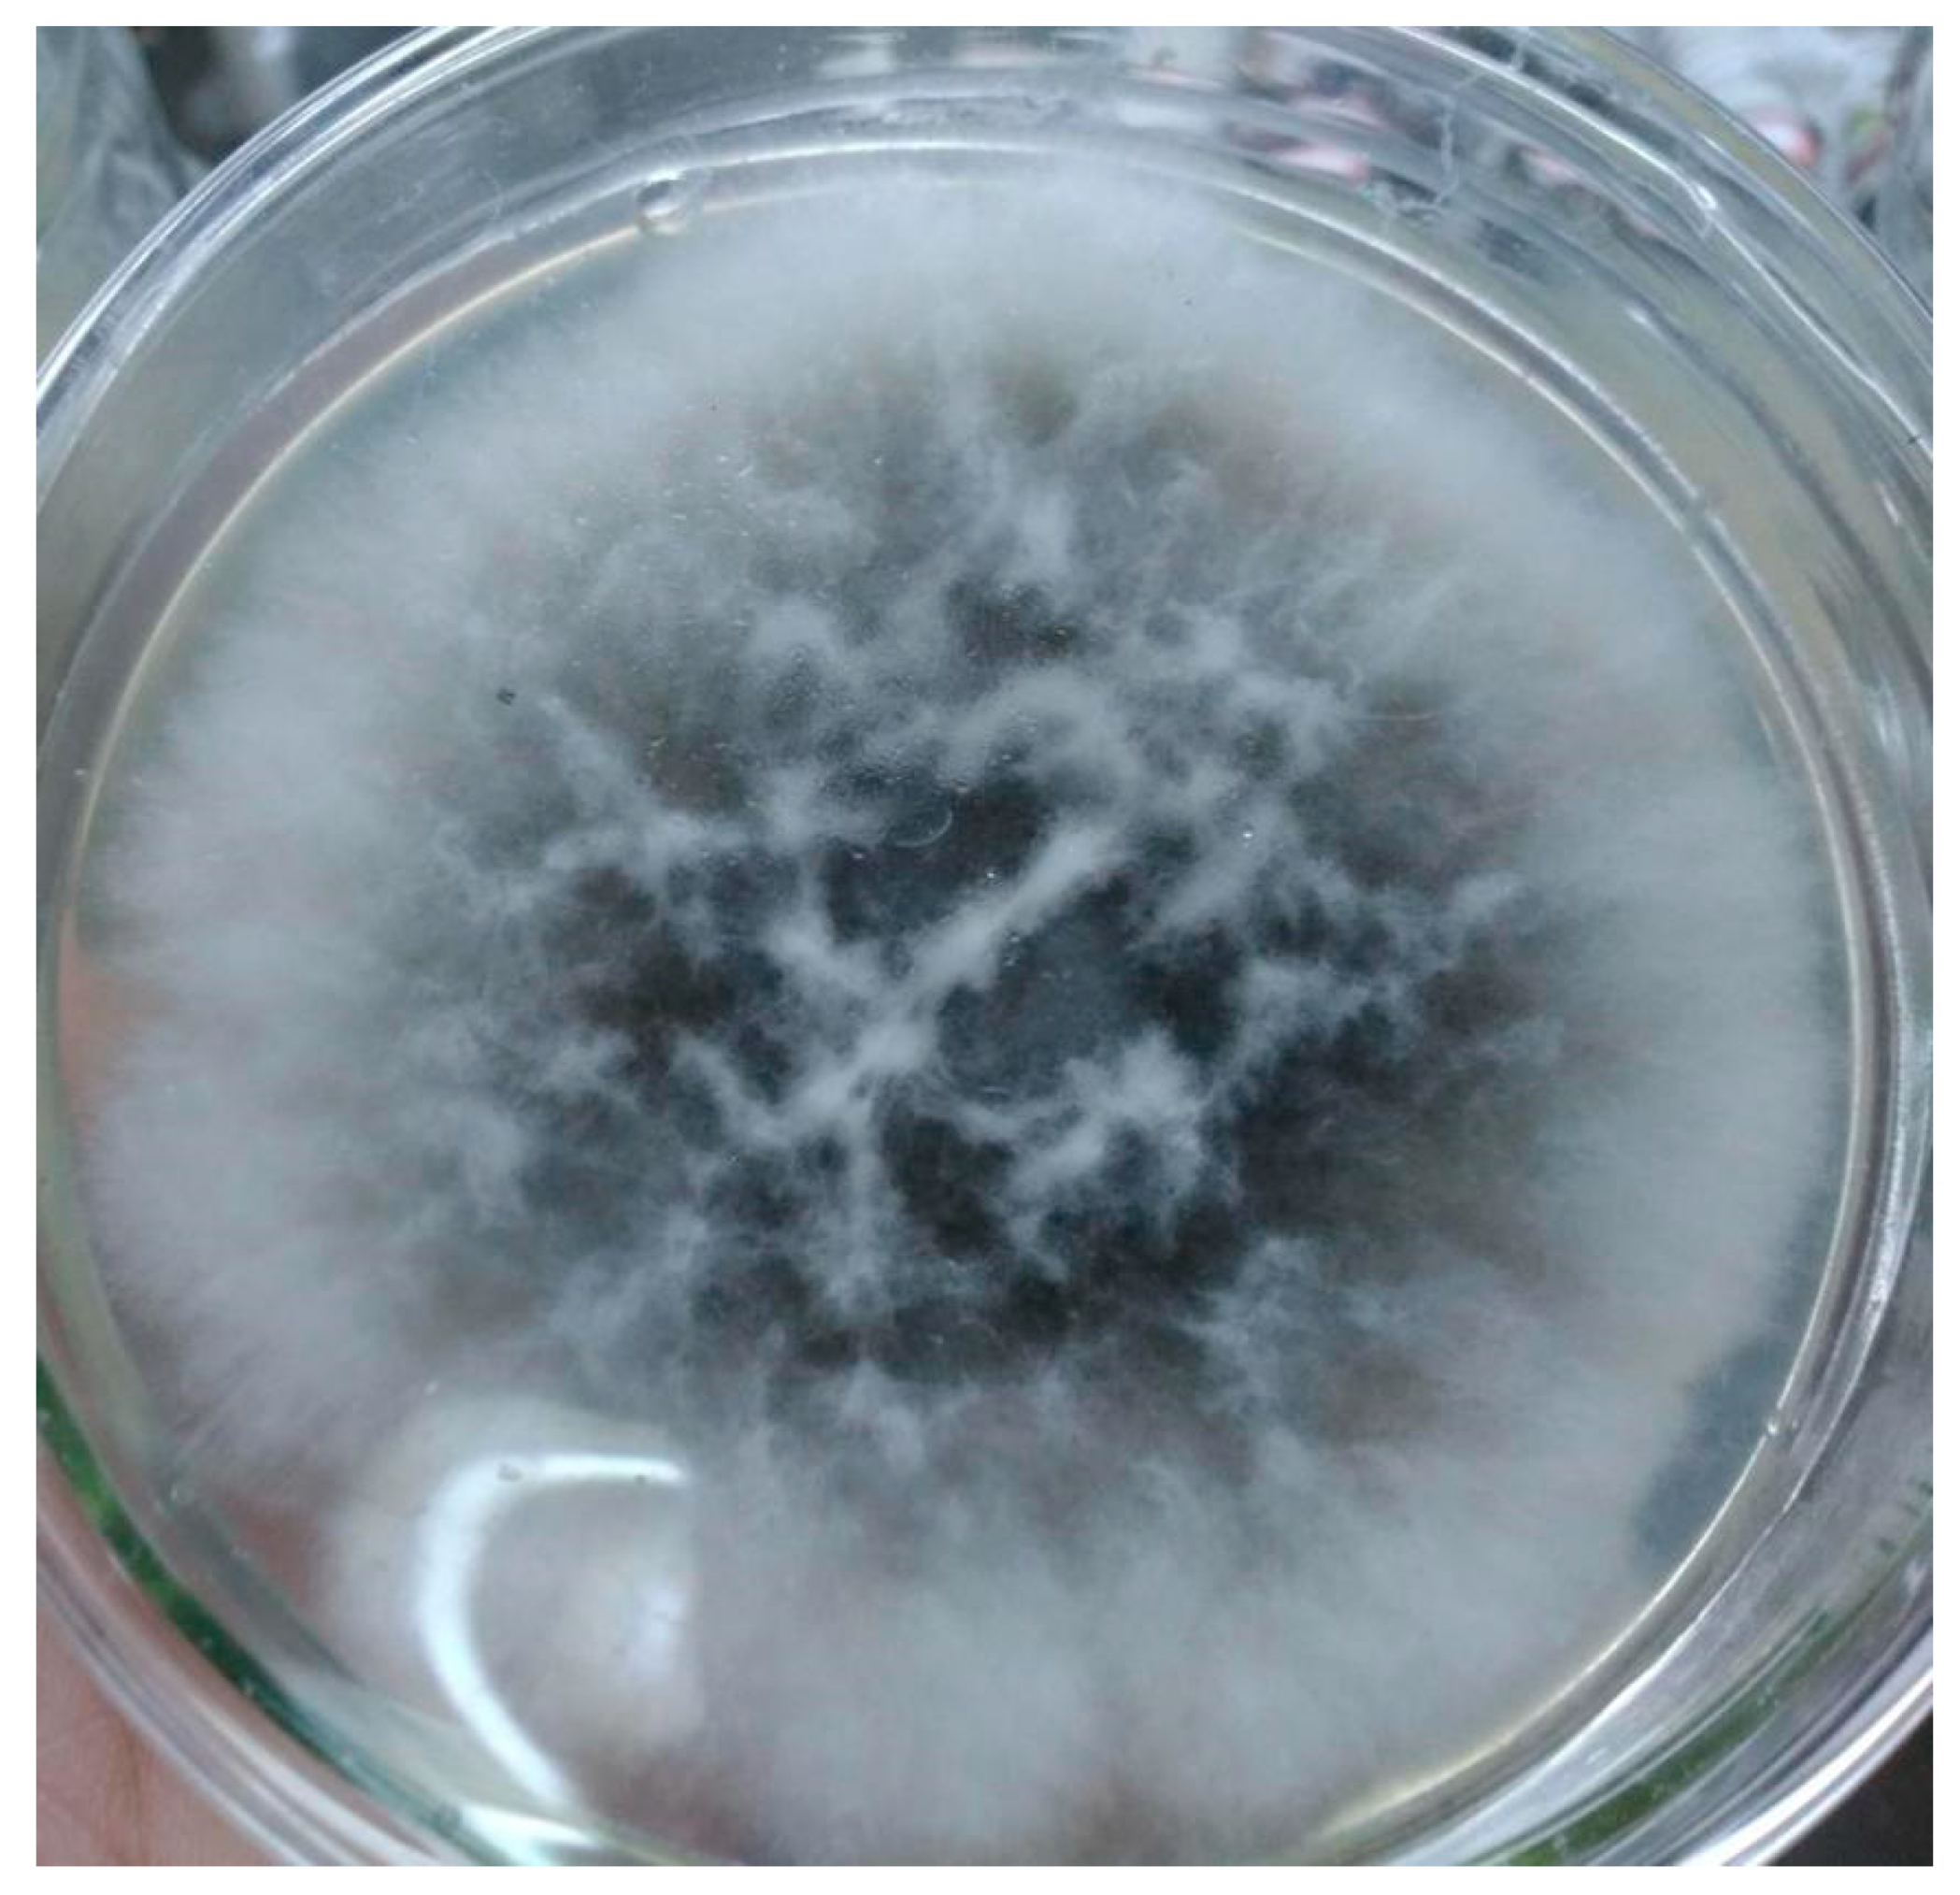
Molecules 23 02586 g003

Optimization of Fermentation Condition for Echinacoside Yield Improvement with Penicillium sp. H1, an Endophytic Fungus Isolated from Ligustrum lucidum Ait Using Response Surface Methodology
Abstract
1. Introduction
2. Results and Discussion
2.1. Identification of Endophyte A. terreus
2.2. HPLC Chromatogram of ECH
2.3. Optimizing the Fermentation Conditions by RSM
3. Materials and Methods
3.1. Reagents and Instruments
3.2. Isolation of Endophytes
3.3. Preparation of Seed Broth
3.4. Ethanol Extract of L. lucidum Ait
3.5. RSM for Optimizing the Fermentation Conditions of ECH
3.6. Analytical Methods
4. Conclusions
Author Contributions
Funding
Conflicts of Interest
References
- Bacon, C.W.; White, J.F., Jr. Microbial Endophytes; Marcel Dekker Inc.: New York, NY, USA, 2000. [Google Scholar]
- Schulz, B.; Boyle, C.; Sieber, T. Microbial Root Endophytes; Springer: Berlin, Germany, 2006. [Google Scholar]
- Card, S.; Johnson, L.; Teasdale, S.; Caradus, J. Deciphering endophyte behaviour: The link between endophyte biology and efficacious biological control agents. FEMS Microbiol. Ecol. 2016, 92, 8. [Google Scholar] [CrossRef] [PubMed]
- Frank, A.C.; Saldierna-Guzmán, J.P.; Shay, J.E. Transmission of Bacterial Endophytes. Microorganisms 2017, 5, 4. [Google Scholar] [CrossRef] [PubMed]
- Wani, Z.A.; Ashraf, N.; Mohiuddin, T.; Riyaz-Ul-Hassan, S. Plant-endophyte symbiosis, an ecological perspective. Appl. Microbiol. Biotechnol. 2015, 99, 2955–2965. [Google Scholar] [CrossRef] [PubMed]
- Liotti, R.G.; da Silva Figueiredo, M.I.; da Silva, G.F.; de Mendonça, E.A.F.; Soares, M.A. Diversity of cultivable bacterial endophytes in Paullinia cupana and their potential for plant growth promotion and phytopathogen control. Microbiol. Res. 2018, 207, 8–18. [Google Scholar] [CrossRef] [PubMed]
- Strobel, G.A. Endophytes as sources of bioactive products. Microbes Infect. 2003, 5, 535–544. [Google Scholar] [CrossRef]
- Aly, A.H.; Debbab, A.; Proksch, P. Fungal endophytes: Unique plant inhabitants with great promises. Appl. Microbiol. Biotechnol. 2011, 90, 1829–1845. [Google Scholar] [CrossRef] [PubMed]
- Busby, P.E.; Soman, C.; Wagner, M.R.; Friesen, M.L.; Kremer, J.; Bennett, A.; Morsy, M.; Eisen, J.A.; Leach, J.E.; Dangl, J.L. Research priorities for harnessing plant microbiomes in sustainable agriculture. PLoS Biol. 2017, 15, e2001793. [Google Scholar] [CrossRef] [PubMed]
- Xu, F.; Wang, S.; Li, Y.; Zheng, M.; Xi, X.; Cao, H.; Cui, X.; Guo, H.; Han, C. Yield enhancement strategies of rare pharmaceutical metabolites from endophytes. Biotechnol. Lett. 2018, 40, 797–807. [Google Scholar] [CrossRef] [PubMed]
- Kuang, R.; Sun, Y.; Zheng, X. Suppression of nitric oxide implicated in the protective effect of echinacoside on H2O2-induced PC12 cell injury. Nat. Prod. Commun. 2010, 5, 571–574. [Google Scholar] [PubMed]
- Xiong, W.T.; Gu, L.; Wang, C.; Sun, H.X.; Liu, X. Anti-hyperglycemic and hypolipidemic effects of Cistanche tubulosa in type 2 diabetic db/db mice. J. Ethnopharmacol. 2013, 150, 935–945. [Google Scholar] [CrossRef] [PubMed]
- Speroni, E.; Govoni, P.; Guizzardi, S.; Renzulli, C.; Guerra, M.C. Anti-inflammatory and cicatrizing activity of Echinacea pallida Nutt. root extract. J. Ethnopharmacol. 2002, 79, 265–272. [Google Scholar] [CrossRef]
- Macková, A.; Mucaji, P.; Widowitz, U.; Bauer, R. In vitro anti-inflammatory activity of Ligustrum vulgare extracts and their analytical characterization. Nat. Prod. Commun. 2013, 8, 1509–1512. [Google Scholar] [PubMed]
- Li, F.; Yang, X.; Yang, Y.; Guo, C.; Zhang, C.; Yang, Z.; Li, P. Antiosteoporotic activity of echinacoside in ovariectomized rats. Phytomedicine 2013, 20, 549–557. [Google Scholar] [CrossRef] [PubMed]
- Li, F.; Yang, Y.; Zhu, P.; Chen, W.; Qi, D.; Shi, X.; Zhang, C.; Yang, Z.; Li, P. Echinacoside promotes bone regeneration by increasing OPG/RANKL ratio in MC3T3-E1 cells. Fitoterapia 2012, 83, 1443–1450. [Google Scholar] [CrossRef] [PubMed]
- Yang, X.; Li, F.; Yang, Y.; Shen, J.; Zou, R.; Zhu, P.; Zhang, C.; Yang, Z.; Li, P. Efficacy and safety of echinacoside in a rat osteopenia model. Evid.-Based Complement. Altern. Med. 2013. [Google Scholar] [CrossRef] [PubMed]
- Zhang, D.; Lu, C.; Yu, Z.; Wang, X.; Yan, L.; Zhang, J.; Li, H.; Wang, J.; Wen, A. Echinacoside Alleviates UVB Irradiation-Mediated Skin Damage via Inhibition of Oxidative Stress, DNA Damage, and Apoptosis. Oxid. Med. Cell Longev. 2017, 2017, 6851464. [Google Scholar] [CrossRef] [PubMed]
- Facino, R.M.; Carini, M.; Aldini, G.; Saibene, L.; Pietta, P.; Mauri, P. Echinacoside and caffeoyl conjugates protect collagen from free radical-induced degradation: A potential use of Echinacea extracts in the prevention of skin photodamage. Planta Med. 1995, 61, 510–514. [Google Scholar] [CrossRef] [PubMed]
- Li, X.; Gou, C.; Yang, H.; Qiu, J.; Gu, T.; Wen, T. Echinacoside ameliorates D-galactosamine plus lipopolysaccharide-induced acute liver injury in mice via inhibition of apoptosis and inflammation. Scand. J. Gastroenterol. 2014, 49, 993–1000. [Google Scholar] [CrossRef] [PubMed]
- Dai, L.H.; Shen, Y.M.; Wu, Y.H.; Yu, X.P.; Hu, H.J.; Mi, Y.J.; Chen, J.J. [Effect of echinacoside on replication and antigen expression of hepatitis B virus]. Zhongguo Zhong Yao Za Zhi 2015, 40, 3047–3052. [Google Scholar] [PubMed]
- Wu, Y.; Li, L.; Wen, T.; Li, Y.Q. Protective effects of echinacoside on carbon tetrachloride-induced hepatotoxicity in rats. Toxicology 2007, 232, 50–56. [Google Scholar] [CrossRef] [PubMed]
- Shiao, Y.J.; Su, M.H.; Lin, H.C.; Wu, C.R. Echinacoside ameliorates the memory impairment and cholinergic deficit induced by amyloid beta peptides via the inhibition of amyloid deposition and toxicology. Food Funct. 2017, 8, 2283–2294. [Google Scholar] [CrossRef] [PubMed]
- Zhang, D.; Li, H.; Wang, J.B. Echinacoside inhibits amyloid fibrillization of HEWL and protects against Aβ-induced neurotoxicity. Int. J. Biol. Macromol. 2015, 72, 243–253. [Google Scholar] [CrossRef] [PubMed]
- Wang, Y.H.; Xuan, Z.H.; Tian, S.; Du, G.H. Echinacoside Protects against 6-Hydroxydopamine-Induced Mitochondrial Dysfunction and Inflammatory Responses in PC12 Cells via Reducing ROS Production. Evid.-Based Complement. Altern. Med. 2015, 2015, 189239. [Google Scholar] [CrossRef] [PubMed]
- Chen, W.; Lin, H.R.; Wei, C.M.; Luo, X.H.; Sun, M.L.; Yang, Z.Z.; Chen, X.Y.; Wang, H.B. Echinacoside, a phenylethanoid glycoside from Cistanche deserticola, extends lifespan of Caenorhabditis elegans and protects from Aβ-induced toxicity. Biogerontology 2017, 19, 47–65. [Google Scholar] [CrossRef] [PubMed]
- Zhang, J.; Zhang, Z.; Xiang, J.; Cai, M.; Yu, Z.; Li, X.; Wu, T.; Cai, D. Neuroprotective Effects of Echinacoside on Regulating the Stress-Active p38MAPK and NF-κB p52 Signals in the Mice Model of Parkinson’s Disease. Neurochem. Res. 2017, 42, 975–985. [Google Scholar] [CrossRef] [PubMed]
- Jiang, Z.; Wang, J.; Li, X.; Zhang, X. Echinacoside and Cistanche tubulosa (Schenk) R. wight ameliorate bisphenol A-induced testicular and sperm damage in rats through gonad axis regulated steroidogenic enzymes. J. Ethnopharmacol. 2016, 193, 321–328. [Google Scholar] [CrossRef] [PubMed]
- Jiang, Z.; Zhou, B.; Li, X.; Kirby, G.M.; Zhang, X. Echinacoside Increases Sperm Quantity in Rats by Targeting the Hypothalamic. Androgen Receptor. Sci. Rep. 2018, 8, 3839. [Google Scholar] [CrossRef] [PubMed]
- Dong, L.; Wang, H.; Niu, J.; Zou, M.; Wu, N.; Yu, D.; Wang, Y.; Zou, Z. Echinacoside induces apoptotic cancer cell death by inhibiting the nucleotide pool sanitizing enzyme MTH1. Onco Targets Ther. 2015, 8, 3649–3664. [Google Scholar] [PubMed]
- Dong, L.; Yu, D.; Wu, N.; Wang, H.; Niu, J.; Wang, Y.; Zou, Z. Echinacoside Induces Apoptosis in Human SW480 Colorectal Cancer Cells by Induction of Oxidative DNA Damages. Int. J. Mol. Sci. 2015, 16, 14655–14668. [Google Scholar] [CrossRef] [PubMed]
- Wang, W.; Luo, J.; Liang, Y.; Li, X. Echinacoside suppresses pancreatic adenocarcinoma cell growth by inducing apoptosis via the mitogen-activated protein kinase pathway. Mol. Med. Rep. 2016, 13, 2613–2618. [Google Scholar] [CrossRef] [PubMed]
- Kuo, C.H.; Hsiao, F.W.; Chen, J.H.; Hsieh, C.W.; Liu, Y.C.; Shieh, C.J. Kinetic aspects of ultrasound-accelerated lipase catalyzed acetylation and optimal synthesis of 4’-acetoxyresveratrol. Ultrason. Sonochem. 2013, 20, 546–552. [Google Scholar] [CrossRef] [PubMed]
- Gu, F.; Xu, F.; Tan, L.; Wu, H.; Chu, Z.; Wang, Q. Optimization of enzymatic process for vanillin extraction using response surface methodology. Molecules 2012, 17, 8753–8761. [Google Scholar] [CrossRef] [PubMed]
- Wu, K.; Ding, L.; Zhu, P.; Li, S.; He, S. Application of the Response Surface Methodology to Optimize the Fermentation Parameters for Enhanced Docosahexaenoic Acid (DHA) Production by sp ATCC 26185. Molecules 2018, 23, 974. [Google Scholar] [CrossRef] [PubMed]
- Wang, Y.; Zhang, M.; Zhang, Z.; Jiang, Z.; Jiang, J.; Gao, X.; Yue, P. Multiple responses optimization of instant dark tea production by submerged fermentation using response surface methodology. J. Food Sci. Technol. 2018, 55, 2579–2586. [Google Scholar] [CrossRef] [PubMed]
- Peiran, L.; Ying, L.; Mingzhuo, Z.; Ye, Y.; Xiuming, C. The development of a Panax notoginseng medicinal liquor processing technology using the response surface method and a study of its antioxidant activity and its effects on mouse melanoma B16 cells. Food Funct. 2017, 8, 4251–4264. [Google Scholar] [CrossRef] [PubMed]
- Wang, W.; Di, Z.; Li, R.; Tian, J. Statistical Optimization of the Content Composition Precursors Using Response Surface Methodology to Enhance Agaricoglyceride A Production from the Shaggy Ink Cap Medicinal Mushroom, Coprinus comatus (Higher Basidiomycetes) Mycelia. Int. J. Med. Mushrooms 2015, 17, 977–985. [Google Scholar] [CrossRef] [PubMed]
- Bodhankar, S.; Grover, M.; Hemanth, S.; Reddy, G.; Rasul, S.; Yadav, S.K.; Desai, S.; Mallappa, M.; Mandapaka, M.; Srinivasarao, C. Maize seed endophytic bacteria: Dominance of antagonistic, lytic enzyme-producing Bacillus spp. 3 Biotech 2017, 7, 232. [Google Scholar] [CrossRef] [PubMed]
- Zhang, Q.; Li, Y.; Xu, F.; Zheng, M.; Xi, X.; Zhang, X.; Han, C. Optimization of Submerged Fermentation Medium for Matrine Production by, an Endophytic Fungus Harboring Seeds of, Using Response Surface Methodology. Mycobiology 2017, 45, 90–96. [Google Scholar] [CrossRef] [PubMed]
- Zhang, Y.J.; Li, Q.; Zhang, Y.X.; Wang, D.; Xing, J.M. Optimization of succinic acid fermentation with Actinobacillus succinogenes by response surface methodology (RSM). J. Zhejiang Univ. Sci. B 2012, 13, 103–110. [Google Scholar] [CrossRef] [PubMed]
Sample Availability: Samples of the compounds are available from the authors. |

| Standard | Run Order | X1 | X2 | X3 | The Yield of ECH | |
|---|---|---|---|---|---|---|
| Experimental | Predicted | |||||
| 3 | 1 | −1 | 1 | 0 | 19.31 | 18.95 |
| 13 | 2 | 0 | 0 | 0 | 36.98 | 36.98 |
| 8 | 3 | 1 | 0 | 1 | 17.21 | 16.99 |
| 7 | 4 | −1 | 0 | 1 | 26.05 | 24.48 |
| 15 | 5 | 0 | 0 | 0 | 37.02 | 36.98 |
| 12 | 6 | 0 | 1 | 1 | 18.34 | 20.26 |
| 17 | 7 | 0 | 0 | 0 | 36.93 | 36.98 |
| 1 | 8 | −1 | −1 | 0 | 17.34 | 19.05 |
| 9 | 9 | 0 | −1 | −1 | 20.03 | 18.11 |
| 10 | 10 | 0 | 1 | −1 | 16.04 | 16.18 |
| 4 | 11 | 1 | 1 | 0 | 16.31 | 14.60 |
| 5 | 12 | −1 | 0 | −1 | 17.21 | 17.43 |
| 6 | 13 | 1 | 0 | −1 | 16.31 | 17.88 |
| 16 | 14 | 0 | 0 | 0 | 36.91 | 36.98 |
| 11 | 15 | 0 | −1 | 1 | 20.33 | 20.19 |
| 2 | 16 | 1 | −1 | 0 | 16.01 | 16.36 |
| 14 | 17 | 0 | 0 | 0 | 37.08 | 36.98 |
| Source | Sum of Squares | df | Mean Square | F-Value | p-Value Probability > F |
|---|---|---|---|---|---|
| Model | 1293.49 | 9 | 143.72 | 54.21 | <0.0001 |
| X1 | 24.75 | 1 | 24.75 | 9.33 | 0.0184 |
| X2 | 1.72 | 1 | 1.72 | 0.65 | 0.4470 |
| X3 | 19.03 | 1 | 19.03 | 7.18 | 0.0316 |
| X1X2 | 0.70 | 1 | 0.70 | 0.26 | 0.6239 |
| X1X3 | 15.76 | 1 | 15.76 | 5.95 | 0.0449 |
| X2X3 | 1.00 | 1 | 1.00 | 0.38 | 0.5585 |
| X12 | 389.32 | 1 | 389.32 | 146.85 | <0.0001 |
| X22 | 431.71 | 1 | 431.71 | 162.84 | <0.0001 |
| X32 | 281.27 | 1 | 281.27 | 106.10 | <0.0001 |
| Residual | 18.56 | 7 | 2.65 | ||
| Lack of fit | 18.54 | 3 | 6.18 | 1306.47 | <0.0001 |
| Pure error | 0.019 | 4 | 4.730 × 10−3 | ||
| Cor total | 1312.05 | 16 |
| Variables | Coded Symbols | Coded Levels | ||
|---|---|---|---|---|
| −1 | 0 | 1 | ||
| Inoculation rate (%) | X1 | 5 | 15 | 25 |
| Temperature (°C) | X2 | 20 | 28 | 36 |
| Days (d) | X3 | 15 | 25 | 35 |
© 2018 by the authors. Licensee MDPI, Basel, Switzerland. This article is an open access article distributed under the terms and conditions of the Creative Commons Attribution (CC BY) license (http://creativecommons.org/licenses/by/4.0/).
Share and Cite
Xu, F.; Cao, H.; Cui, X.; Guo, H.; Han, C. Optimization of Fermentation Condition for Echinacoside Yield Improvement with Penicillium sp. H1, an Endophytic Fungus Isolated from Ligustrum lucidum Ait Using Response Surface Methodology. Molecules 2018, 23, 2586. https://doi.org/10.3390/molecules23102586
Xu F, Cao H, Cui X, Guo H, Han C. Optimization of Fermentation Condition for Echinacoside Yield Improvement with Penicillium sp. H1, an Endophytic Fungus Isolated from Ligustrum lucidum Ait Using Response Surface Methodology. Molecules. 2018; 23(10):2586. https://doi.org/10.3390/molecules23102586
Chicago/Turabian StyleXu, Fangxue, Hui Cao, Xiaowei Cui, Hong Guo, and Chunchao Han. 2018. "Optimization of Fermentation Condition for Echinacoside Yield Improvement with Penicillium sp. H1, an Endophytic Fungus Isolated from Ligustrum lucidum Ait Using Response Surface Methodology" Molecules 23, no. 10: 2586. https://doi.org/10.3390/molecules23102586
APA StyleXu, F., Cao, H., Cui, X., Guo, H., & Han, C. (2018). Optimization of Fermentation Condition for Echinacoside Yield Improvement with Penicillium sp. H1, an Endophytic Fungus Isolated from Ligustrum lucidum Ait Using Response Surface Methodology. Molecules, 23(10), 2586. https://doi.org/10.3390/molecules23102586

